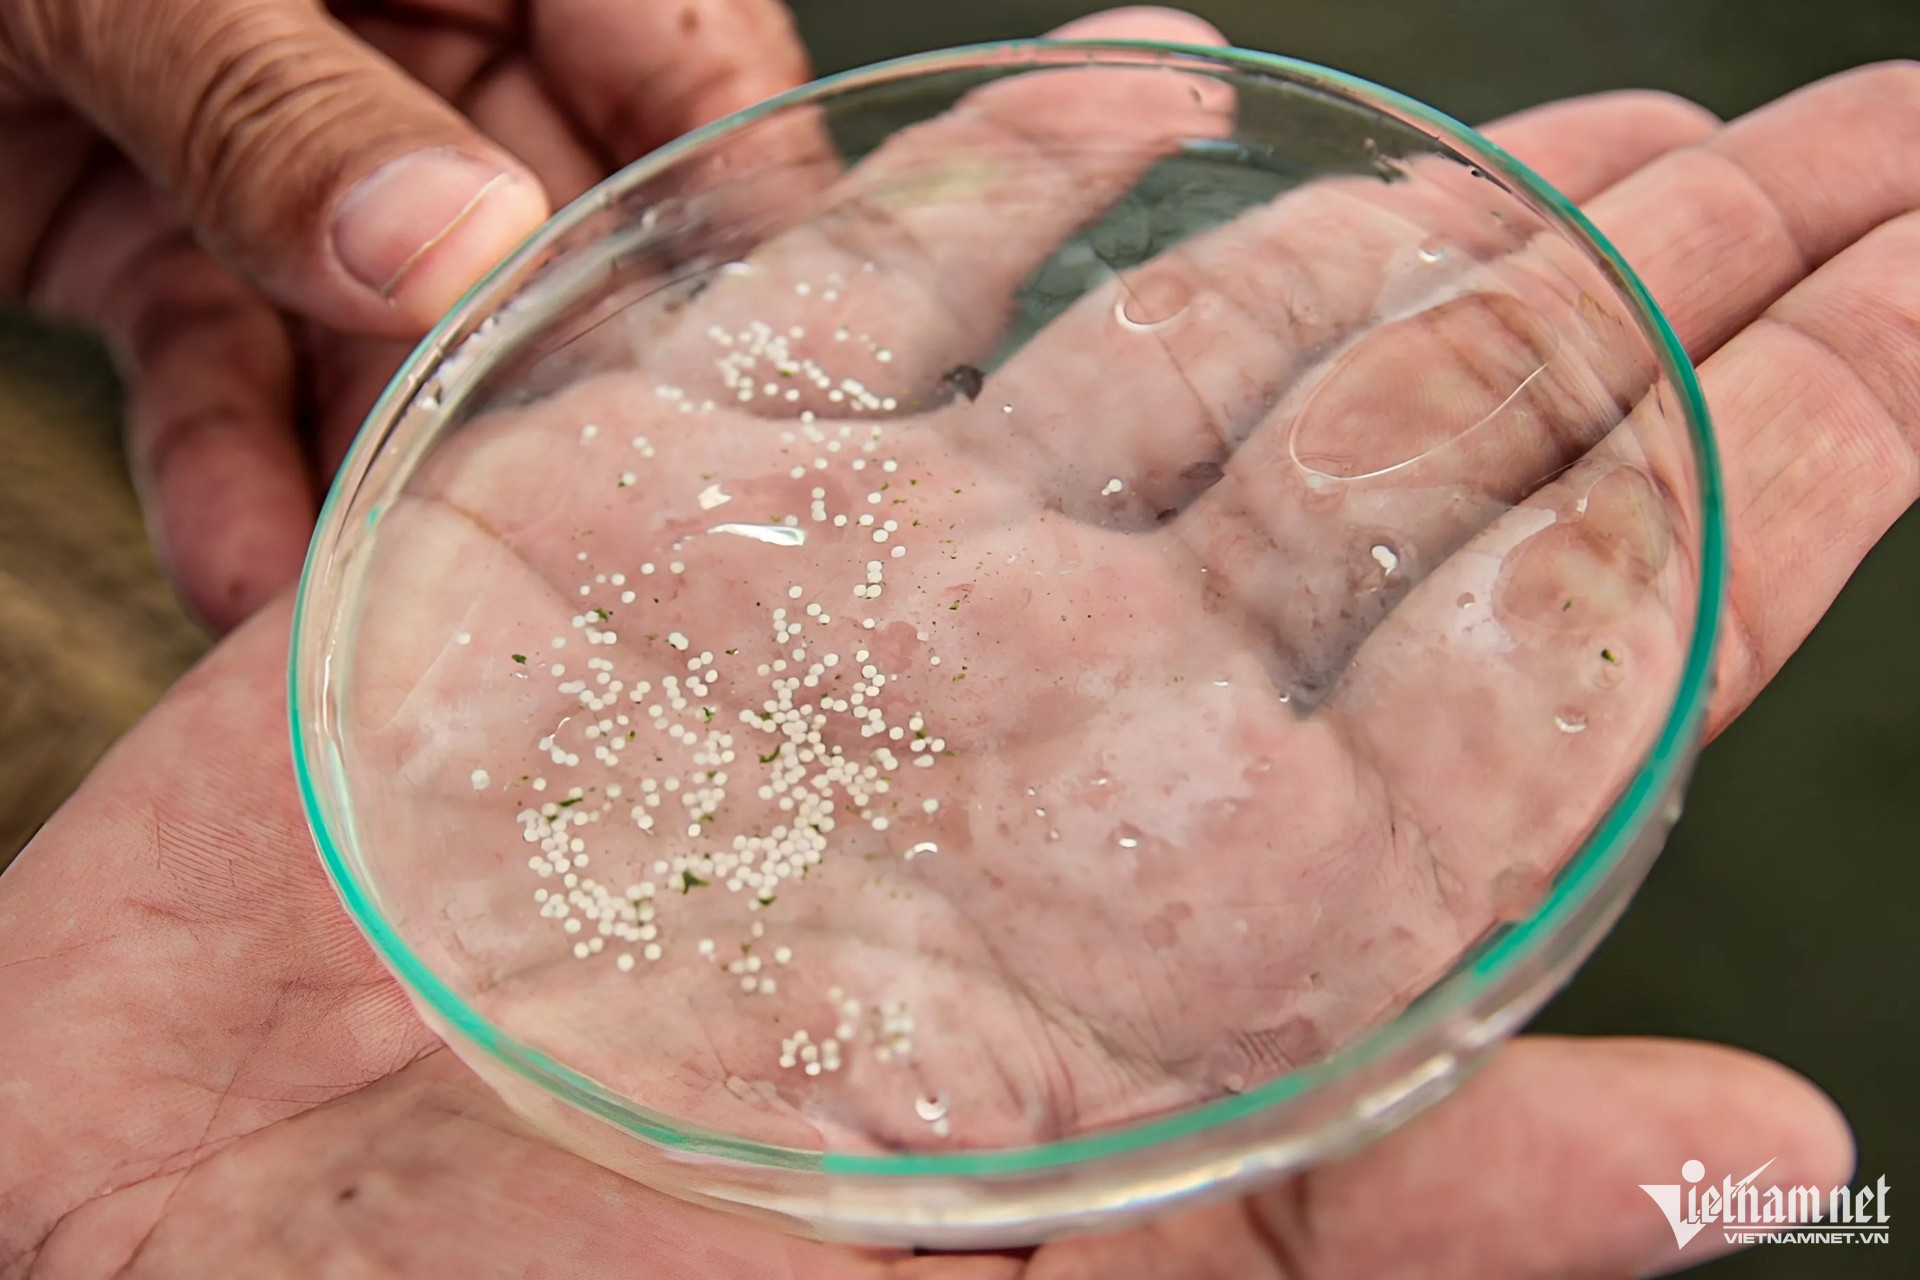

An Giang là một trong những tỉnh ở ĐBSCL đi đầu ứng dụng công nghệ 4.0 vào quản lý chăn nuôi và thú y, từ đó đề ra chiến lược phát triển chăn nuôi phù hợp thực tế, khả thi, tăng hiệu quả chăn nuôi.
Thời gian qua, nghề nuôi cá tra vùng đồng bằng sông Cửu Long luôn được giữ vững, phát triển ổn định trước những thách thức, mối nguy về ô nhiễm môi trường, mầm bệnh, ảnh hưởng của diễn tiến biến đổi khí hậu…

Đến nay, An Giang đã triển khai và hình thành được 3 chuỗi liên kết sản xuất giống cá tra 3 cấp, với thành phần, gồm: Viện Nghiên cứu Nuôi trồng thủy sản II (cấp 1), Trung tâm Giống thủy sản và các cơ sở vệ tinh sản xuất cá tra bột (cấp 2) và các chi hội ương giống cá tra (cấp 3). Hàng năm, địa phương này sản xuất và cung cấp khoảng 4,5 - 5 tỷ cá tra bột và khoảng 0,8 - 1 tỷ cá tra giống.

Theo Sở NN&PTNT, hiện có 4 doanh nghiệp tham gia Đề án cá tra 3 cấp đã xây dựng các vùng ương giống tập trung. Với tổng diện tích 442ha, năng lực sản xuất hàng năm 1,8 tỷ con cá hương và cá giống.
Trong đó, vùng ươm giống tập trung của Công ty cổ phần cá tra Việt Úc, đến nay đã cơ bản hoàn thành các hạng mục đầu tư và đưa vào sản xuất thương mại từ năm 2023. Dự kiến, doanh nghiệp này sản xuất và cung cấp ra thị trường khoảng 50 triệu con giống/năm.
![]() |
![]() |

Trong chương trình chọn giống cá bố mẹ, hầu hết các dữ liệu được thu thập tự động và trực tuyến thông qua các phần mềm, từ đó đưa ra các dự báo và lời khuyên để vận hành chương trình chọn giống một cách tối ưu.

Theo ông Võ Minh Khôi, Giám đốc Công ty cổ phần Cá tra Việt Úc, doanh nghiệp này đã chọn lọc được thế hệ cá tra thứ 3 và đang thực hiện việc chọn lọc thế hệ thứ 4. Theo phân tích dữ liệu của Viện Nghiên cứu Nuôi trồng Thủy sản II, các cá bố mẹ thế hệ thứ 3 của Việt Úc đã tăng trưởng nhanh hơn 30% so với thế hệ ban đầu, và dự báo thế hệ thứ 4 có thể tăng trưởng nhanh hơn 40%.

Việc ứng dụng công nghệ cao trong quy trình nuôi trồng, cùng với hệ thống quan trắc môi trường tự động đến công nghệ chip điện tử định danh cá, những đổi mới này đã góp phần nâng cao chất lượng sản phẩm, đáp ứng các tiêu chuẩn khắt khe của thị trường xuất khẩu.

Với những số liệu chính xác đã hỗ trợ tốt cho công tác kiểm tra, giám sát, phòng ngừa, khoanh vùng và kiểm soát dịch bệnh thuận lợi hơn.

Cá tra là đối tượng nuôi nước ngọt phổ biến ở vùng ĐBSCL, đồng thời là sản phẩm xuất khẩu chủ lực của ngành thủy sản Việt Nam sau con tôm. Hình thành liên kết sản xuất giống cá tra 3 cấp chất lượng cao tại An Giang đang góp phần để con cá tra phát triển bền vững.

Theo ông Trần Thanh Hiệp, Phó Giám đốc Sở NN&PTNN tỉnh An Giang, việc ứng dụng phần mềm, cơ sở dữ liệu chăn nuôi giúp công tác báo cáo và kiểm soát dịch bệnh trên vật nuôi được thuận lợi hơn đối với cơ quan quản lý. Qua đó, cơ quan chức năng quản lý của tỉnh có thể thông tin kịp thời, khuyến cáo địa phương, cá nhân, cơ sở, doanh nghiệp chăn nuôi chủ động phòng trừ dịch bệnh.